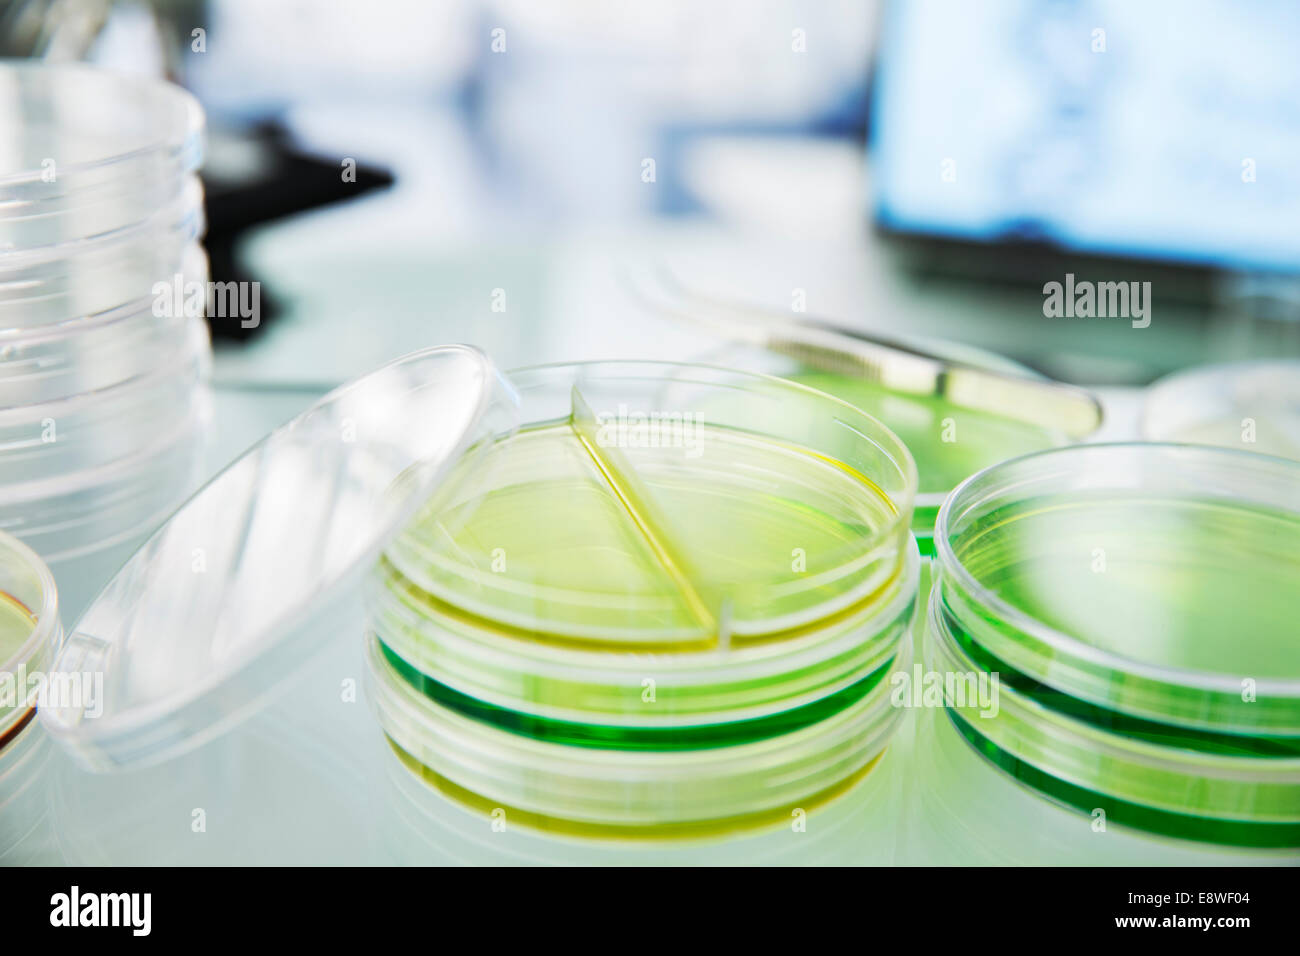
Close up of cultures dans des boîtes de Pétri sur counter in lab Banque D'Images

Close up of cultures dans des boîtes de Pétri sur counter in lab
RFID:ID de l’image:E8WF04
Détails de l'image
Contributeur:
Fredrick KippeID de l’image:
E8WF04Taille du fichier:
50 MB (792,5 KB Téléchargement compressé)Autorisations:
Modèle - non | Propriété - nonUne autorisation est-elle nécessaire?Dimensions:
5120 x 3413 px | 43,3 x 28,9 cm | 17,1 x 11,4 inches | 300dpiDate de la prise de vue:
2014Lieu:
StudioInformations supplémentaires: